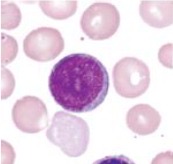
term image

1/14
Looks like no tags are added yet.
Name | Mastery | Learn | Test | Matching | Spaced | Call with Kai |
|---|
No analytics yet
Send a link to your students to track their progress


Monocyte

Red blood cell

Platelet

P. falciparum

P. vivax

P. malariae

P. ovale

P. knowlesi

Myeloblast
Myeloblast

Promyelocyte

Neutrophilic myelocyte

Neutrophilic myelocyte
